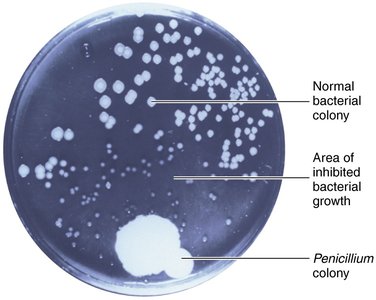
Petri dish showing Penicillium inhibiting bacterial growth

BackChapter 1: The Microbial World and You – Study Notes
Study Guide - Smart Notes
Tailored notes based on your materials, expanded with key definitions, examples, and context.
Chapter 1: The Microbial World and You
Introduction to Microbiology
Microbiology is the study of microorganisms, a diverse group of microscopic life forms that include bacteria, archaea, fungi, protozoa, algae, viruses, and some multicellular parasites. These organisms play essential roles in ecosystems, human health, and industry.

What is a Microbe?
Microbes are organisms that are typically too small to be seen with the unaided eye, though some exceptions exist. They can be unicellular, multicellular, or acellular, and include both prokaryotic and eukaryotic forms.
Bacteria: Prokaryotic, single-celled organisms with peptidoglycan cell walls.
Fungi: Eukaryotic organisms, including unicellular yeasts and multicellular molds and mushrooms.
Protozoa: Eukaryotic, mostly unicellular organisms, often motile.
Algae: Eukaryotic, photosynthetic organisms with cellulose cell walls.
Viruses: Acellular entities with DNA or RNA, requiring a host cell for replication.
Multicellular Animal Parasites: Eukaryotic, multicellular organisms such as helminths, with some microscopic stages.

Microbes in Our Lives
Microorganisms are vital to life on Earth. While a few are pathogenic, most are beneficial and perform essential functions:
Decompose organic waste
Generate oxygen via photosynthesis
Produce chemicals (e.g., ethanol, acetone, vitamins)
Ferment foods (e.g., cheese, bread, vinegar)
Used in manufacturing and disease treatment (e.g., insulin)
Prevent food spoilage and disease
The Microbiome
The microbiome refers to the community of microorganisms that inhabit a particular environment, such as the human body. Normal intestinal bacteria, for example, aid in digestion and protect against pathogens.

Naming and Classifying Microorganisms
Scientific nomenclature, established by Carolus Linnaeus, assigns each organism a two-part name: the genus (capitalized) and the specific epithet (lowercase), both italicized or underlined. For example, Escherichia coli.
Major Groups of Microorganisms
Bacteria
Prokaryotic, single-celled
Peptidoglycan cell walls
Divide by binary fission
Obtain nutrition from organic/inorganic chemicals or photosynthesis
May be motile via flagella

Archaea
Prokaryotic, lack peptidoglycan in cell walls
Often live in extreme environments (e.g., methanogens, halophiles, thermophiles)
Not known to cause human disease
Fungi
Eukaryotic, chitin cell walls
Absorb organic chemicals for energy
Yeasts (unicellular), molds and mushrooms (multicellular)
Molds form mycelia composed of hyphae

Protozoa
Eukaryotic, unicellular
Absorb or ingest organic chemicals
Motile via pseudopods, cilia, or flagella
Free-living or parasitic; some are photosynthetic
Reproduce sexually or asexually

Algae
Eukaryotic, cellulose cell walls
Photosynthetic, produce oxygen and carbohydrates
Found in freshwater, saltwater, and soil
Reproduce sexually and asexually

Viruses
Acellular, consist of DNA or RNA core
Core surrounded by protein coat, sometimes with lipid envelope
Replicate only inside living host cells
Inert outside living hosts

Multicellular Animal Parasites
Eukaryotic, multicellular animals
Include helminths (flatworms and roundworms)
Some life stages are microscopic
Classification of Microorganisms
Carl Woese developed the three-domain system based on cellular organization:
Bacteria
Archaea
Eukarya (includes protists, fungi, plants, animals)
Historical Foundations of Microbiology
The First Observations
1665: Robert Hooke observed "cells" in cork, beginning cell theory.
1623–1673: Anton van Leeuwenhoek observed "animalcules" (microbes) with simple microscopes.

The Debate over Spontaneous Generation
Spontaneous generation was the hypothesis that life could arise from nonliving matter. This was challenged by the concept of biogenesis, which states that living cells arise only from preexisting cells.
1858: Rudolf Virchow proposed biogenesis.
Disproving Spontaneous Generation
Louis Pasteur's experiments with swan-necked flasks demonstrated that microorganisms do not arise spontaneously, but from other microbes in the environment.

The Germ Theory of Disease
The germ theory states that microorganisms are the cause of many diseases. Key contributors include:
Agostino Bassi (1835): Fungus caused silkworm disease.
Louis Pasteur (1865): Protozoan caused another silkworm disease.
Ignaz Semmelweis (1840s): Advocated handwashing to prevent puerperal fever.
Joseph Lister (1860s): Used phenol to prevent surgical infections.
Robert Koch (1876): Developed Koch's postulates to link specific microbes to specific diseases.

Prevention and Treatment of Diseases
Vaccination
1796: Edward Jenner developed the first vaccine (cowpox for smallpox).

Chemotherapy and Antibiotics
Chemotherapy: Treatment of disease with chemicals (synthetic drugs or antibiotics).
Antibiotics: Chemicals produced by microbes that inhibit or kill other microbes.
1928: Alexander Fleming discovered penicillin from Penicillium fungus.
1940s: Penicillin mass-produced for clinical use.
Branches of Microbiology
Bacteriology: Study of bacteria
Mycology: Study of fungi
Parasitology: Study of protozoa and parasitic worms
Immunology: Study of immunity
Virology: Study of viruses
Microbial genetics: Study of microbial inheritance
Molecular biology: Study of DNA-directed protein synthesis
Modern Microbiology: Applications and Impact
Recycling Vital Elements
Microbial ecology studies the interactions between microbes and their environment. Microbes recycle elements such as carbon, nitrogen, sulfur, and phosphorus, making them available to plants and animals.
Bioremediation
Microbes degrade organic matter in sewage and detoxify pollutants like oil and mercury, contributing to environmental cleanup.

Biotechnology and Recombinant DNA Technology
Biotechnology: Use of microbes for practical applications (e.g., food production, chemical synthesis).
Recombinant DNA technology: Genetic engineering of microbes to produce proteins, vaccines, and enzymes.
Normal Microbiota and Biofilms
Normal microbiota: Microbes that inhabit the human body, providing protection and nutrients.
Biofilms: Microbial communities attached to surfaces, often resistant to antibiotics and causing persistent infections.
Emerging Infectious Diseases (EIDs)
Emerging infectious diseases are new or increasing in incidence. Examples include:
Viral: Zika, MERS, SARS, COVID-19, H1N1, H5N1, Ebola, Marburg, HIV
Bacterial: MRSA, Clostridium difficile
Summary Table: Major Groups of Microorganisms
Group | Cell Type | Cell Wall | Reproduction | Nutrition | Example |
|---|---|---|---|---|---|
Bacteria | Prokaryotic | Peptidoglycan | Binary fission | Organic/inorganic/photosynthesis | Escherichia coli |
Archaea | Prokaryotic | None or pseudomurein | Binary fission | Various | Methanogens |
Fungi | Eukaryotic | Chitin | Spores/budding | Absorption | Yeast, mold |
Protozoa | Eukaryotic | None | Sexual/asexual | Absorption/ingestion | Amoeba |
Algae | Eukaryotic | Cellulose | Sexual/asexual | Photosynthesis | Volvox |
Viruses | Acellular | None | Host cell machinery | Host cell | HIV, Zika |
Helminths | Eukaryotic | None | Sexual | Ingestion/absorption | Tapeworm |